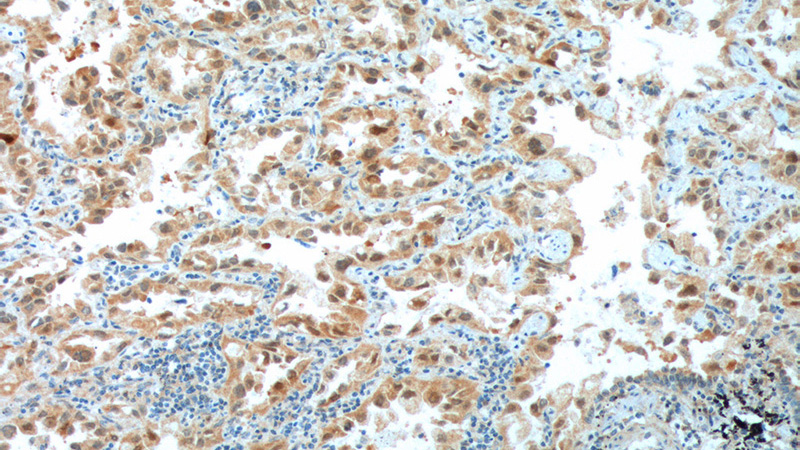
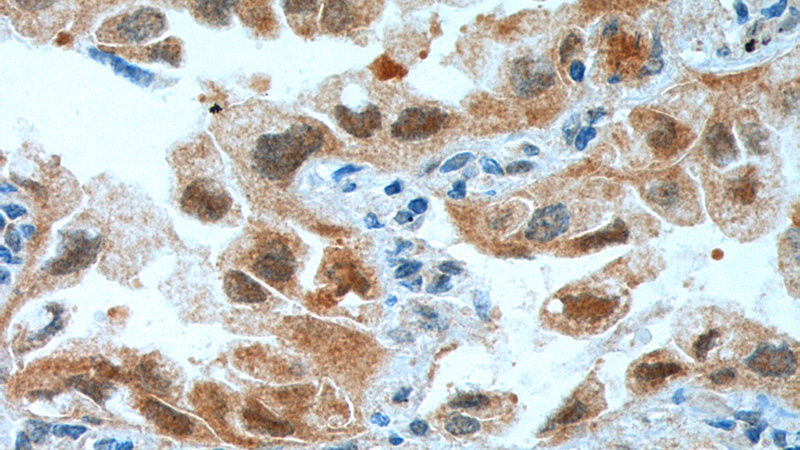

-
Product Name
CDK4 antibody
- Documents
-
Description
CDK4 Rabbit Polyclonal antibody. Positive FC detected in MCF-7 cells. Positive IHC detected in human lung cancer tissue, human breast cancer tissue, human lymphoma tissue. Positive IF detected in MCF-7 cells. Positive IP detected in HeLa cells. Positive WB detected in HeLa cells, HepG2 cells, rat pancreas tissue. Observed molecular weight by Western-blot: 34 kDa
-
Tested applications
ELISA, WB, IF, FC, IP, IHC
-
Species reactivity
Human,Mouse,Rat; other species not tested.
-
Alternative names
CDK4 antibody; Cell division protein kinase 4 antibody; CMM3 antibody; cyclin dependent kinase 4 antibody; PSK J3 antibody
-
Isotype
Rabbit IgG
-
Preparation
This antibody was obtained by immunization of CDK4 recombinant protein (Accession Number: NM_000075). Purification method: Antigen affinity purified.
-
Clonality
Polyclonal
-
Formulation
PBS with 0.1% sodium azide and 50% glycerol pH 7.3.
-
Storage instructions
Store at -20℃. DO NOT ALIQUOT
-
Applications
Recommended Dilution:
WB: 1:500-1:5000
IP: 1:500-1:5000
IHC: 1:20-1:200
IF: 1:20-1:200
-
Validations

HeLa cells were subjected to SDS PAGE followed by western blot with Catalog No:109161(CDK4 antibody) at dilution of 1:1000

Immunofluorescent analysis of MCF-7 cells, using CDK4 antibody Catalog No:109161 at 1:50 dilution and FITC-labeled donkey anti-rabbit IgG(green). Blue pseudocolor = DAPI (fluorescent DNA dye)

IP Result of anti-CDK4 (IP:Catalog No:109161, 3ug; Detection:Catalog No:109161 1:1000) with HeLa cells lysate 4000ug.
Immunohistochemistry of paraffin-embedded human lung cancer tissue slide using Catalog No:109161(CDK4 Antibody) at dilution of 1:200 (under 10x lens). heat mediated antigen retrieved with Tris-EDTA buffer(pH9).
Immunohistochemistry of paraffin-embedded human lung cancer tissue slide using Catalog No:109161(CDK4 Antibody) at dilution of 1:200 (under 40x lens). heat mediated antigen retrieved with Tris-EDTA buffer(pH9).

1X10^6 MCF-7 cells were stained with 0.2ug CDK4 antibody (Catalog No:109161, red) and control antibody (blue). Fixed with 90% MeOH blocked with 3% BSA (30 min). Alexa Fluor 488-congugated AffiniPure Goat Anti-Rabbit IgG(H+L) with dilution 1:1000.
-
Background
Cyclin-dependent kinase-4 (CDK4) is a protein-serine kinase involved in the cell cycle. It is essential for the G1- to S-phase transition during the cell cycle and its expression is primarily controlled at the transcriptional level(PMID:17253961). CCND1-CDK4 axis is not only critical in glial tumor cells but also in stromal-derived cells in the surrounding tumor microenvironment that are vital to sustain tumor outgrowth(PMID:21844184).
-
References
- Zhang Y, Fei M, Xue G. Elevated levels of hypoxia-inducible microRNA-210 in pre-eclampsia: new insights into molecular mechanisms for the disease. Journal of cellular and molecular medicine. 16(2):249-59. 2012.
- Wang Z, Liu F, Tu W. Embryonic liver fodrin involved in hepatic stellate cell activation and formation of regenerative nodule in liver cirrhosis. Journal of cellular and molecular medicine. 16(1):118-28. 2012.
- Hu HM, Chen Y, Liu L. C1orf61 acts as a tumor activator in human hepatocellular carcinoma and is associated with tumorigenesis and metastasis. FASEB journal : official publication of the Federation of American Societies for Experimental Biology. 27(1):163-73. 2013.
- Sun Q, Wang R, Wang Y, Luo J, Wang P, Cheng B. Notch1 is a potential therapeutic target for the treatment of human hepatitis B virus X protein-associated hepatocellular carcinoma. Oncology reports. 31(2):933-9. 2014.
- Song Y, Gong K, Yan H. Sj7170, a unique dual-function peptide with a specific α-chymotrypsin inhibitory activity and a potent tumor-activating effect from scorpion venom. The Journal of biological chemistry. 289(17):11667-80. 2014.
- Ning Z, Wang A, Liang J. USP22 promotes the G1/S phase transition by upregulating FoxM1 expression via β-catenin nuclear localization and is associated with poor prognosis in stage II pancreatic ductal adenocarcinoma. International journal of oncology. 45(4):1594-608. 2014.
- Xiao W, Jiang Y, Men Q. Tetrandrine induces G1/S cell cycle arrest through the ROS/Akt pathway in EOMA cells and inhibits angiogenesis in vivo. International journal of oncology. 46(1):360-8. 2015.
- Shan X, Fu YS, Aziz F, Wang XQ, Yan Q, Liu JW. Ginsenoside Rg3 inhibits melanoma cell proliferation through down-regulation of histone deacetylase 3 (HDAC3) and increase of p53 acetylation. PloS one. 9(12):e115401. 2014.
Related Products / Services
Please note: All products are "FOR RESEARCH USE ONLY AND ARE NOT INTENDED FOR DIAGNOSTIC OR THERAPEUTIC USE"
